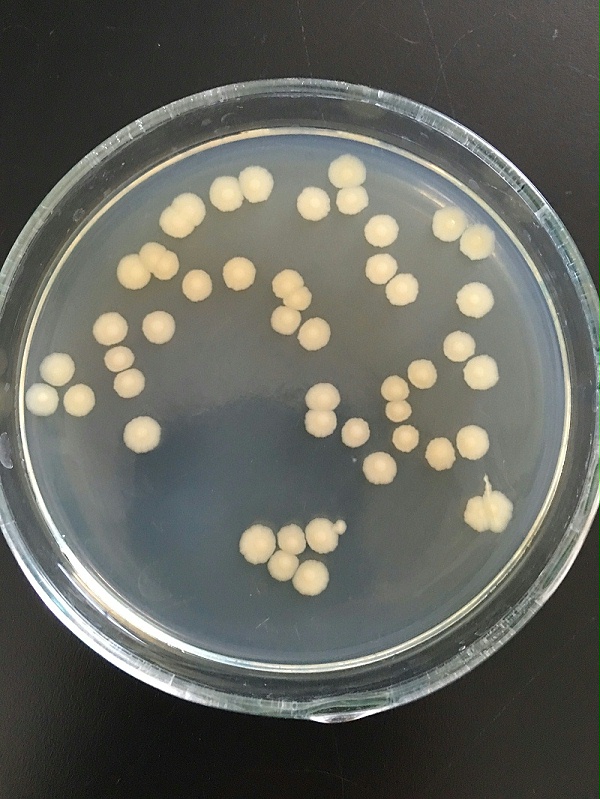
巨大芽孢杆菌1

巨大芽孢杆菌是革兰氏阳性细菌,其转化方法与革兰氏阴性细菌不同。一般有原生质体转化法和电击转化法。巨大芽孢杆菌的原生质体转化法是由PEG-6000介导的。原生质体转化法比较复杂,巨大芽孢杆菌在溶菌酶的作用下转化为原生质体,构建好地携带外源基因的质粒转化巨大芽孢杆菌中。电击转化法简单快速转化效率高,可有效地将DNA转入巨大芽孢杆菌中,是最常用的转化方法。
近年关于巨大芽孢杆菌生防作用的研究较多,巨大芽孢杆菌B196可以抑制水稻纹枯病菌、水稻细菌性条斑病菌、水稻白叶枯病、番茄青枯病菌、烟草赤星病菌、玉米白绢病菌和西瓜枯萎病菌等病原菌的生长。能抑制黄曲霉的生长,并能抑制在花生上黄曲霉毒素的生物合成,其机理为通过竞争性生长和产生某种次级代谢产物,抑制黄曲霉的生长和黄曲霉毒素合成基因的表达。巨大芽孢杆菌的生防作用应用到农业中,可以减少农药的使用,减低农资成本,并可以间接地降低农产品的农药残留,具有非常重要的作用。
巨大芽孢杆菌除了具有解磷作用、生物防治作用、水体净化作用、和表达外源蛋白作用外,还有一些作用逐渐被发现。如有降解泡叶藻的作用,具有海藻胶裂解酶、蛋白酶和纤维素酶活性,将构成海藻的大分子物质降解成小分子、水溶性的物质,最大限度完整地保留了海藻中的生物活性物质和营养物质,有望取代传统的物理法和化学法,采用生物法进行海藻降解。
